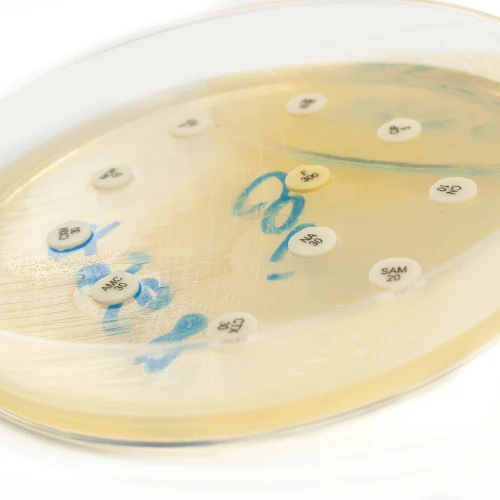
Imagen de: MOCO NASAL, EXUDADO FARINGEO, HECES, ORINA, EXUDADO VAGINAL

Servicios
Descripción
El cultivo antibiograma es un análisis de laboratorio que se realiza para identificar microorganismos presentes en muestras biológicas, como moco nasal, exudado faríngeo, heces, orina y exudado vaginal, y determinar su sensibilidad a diferentes antibióticos.
En el caso del moco nasal y el exudado faríngeo, estas muestras se toman de la nariz y la garganta, respectivamente, y se analizan para identificar la presencia de bacterias que pueden causar infecciones respiratorias, como sinusitis, faringitis o amigdalitis. El cultivo antibiograma ayuda a seleccionar el tratamiento antibiótico más efectivo si se determina que la infección es bacteriana.
Para las heces, el cultivo antibiograma se utiliza para detectar la presencia de bacterias patógenas en el tracto gastrointestinal, lo que puede indicar infecciones intestinales, como la salmonelosis o la infección por E. coli. Para la orina, se utiliza para diagnosticar infecciones del tracto urinario (ITU), como la cistitis o la pielonefritis, al identificar bacterias en la muestra de orina. Y en el caso del exudado vaginal, se busca identificar microorganismos que puedan estar causando infecciones vaginales, como la candidiasis o la vaginosis bacteriana.
El análisis del cultivo antibiograma proporciona información crucial para seleccionar el tratamiento antibiótico adecuado, ya que ayuda a identificar qué antibióticos son efectivos contra los microorganismos específicos presentes en la muestra. Esto es fundamental para combatir la infección y prevenir la resistencia bacteriana. Los resultados del cultivo antibiograma se interpretan junto con otros hallazgos clínicos para determinar el tratamiento más apropiado para el paciente.
Indicaciones

Quimoto Análisis Clínicos
Quimoto Análisis Clínicos